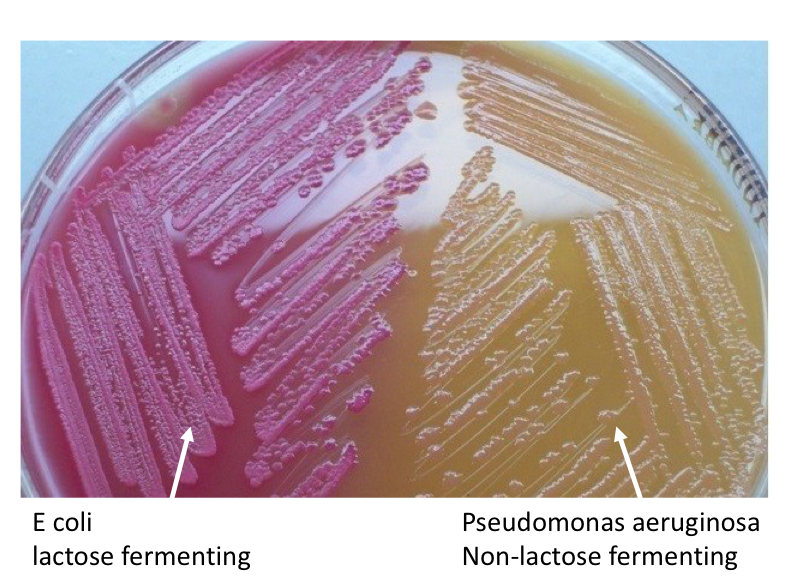

What are the features of EColi e.g shape and gram stain?
Enterobacteriaceae means it can use lactose

What would E Coli look like under the microscope?

How can you identify E.Coli without a gram stain in the lab?
MacConkey agar containing lactose. If they use lactose they produce lactic acid and this turns the agar red as it has a low pH. If not lactose fermenting they grow yellow colonies
How can you distinguish between different strains of E.coli?

Where are the different antigens on E.Coli?

What are some of the diseases that E.Coli can cause?
What are the most common strains of E.Coli that cause diarrhoea?

What is the major cause of traveller’s diarrhoea and how does it cause disease?

What complications does shiga toxin producing E coli cause?

How does the Shiga Toxin cause virulence?

What are some of the virulence factors of E.coli (ExPEC)?

How does E.coli cause urinary infections?
- UPC has adhesins called type 1 fimbria that can bind to uroepithelium to form communities, LPS toxin, cytotoxin alpha-haemolysin and produce siderophores to sequester iron to survive

Apart from UTIs and diarrhoea what other common infection can E.Coli cause?
Most common cause of blood stream infection leading to SEPSIS

How can you prevent and treat traveller’s diarrhoea?
Prevent:
Treatment:
How can you treat UTI caused by E. COLI?
What antibiotic should you not use for E.Coli blood stream infections?